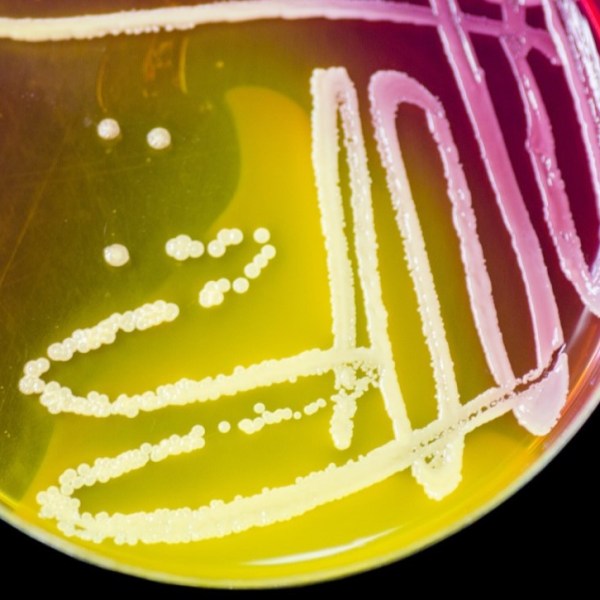
Waarom wetenschappers GGO’s maken voor onderzoek in het&nbsp;laboratorium

De nieuwste blogs
Goed genoeg
Eind december lijkt het uitgelezen moment voor reflectie en nieuwe plannen. Is dat wel zo goed?
Ik wil dat jij je handen wast!
Het aantal mensen dat zich ziek meldde tijdens is coronacrisis is afgenomen door social distancing en betere hygiëne. Dus waarom zetten we deze maatregelen niet om in gewoontes waar we ons aan houden, zelfs na de pandemie?
Een appel of een pil per dag, wat houdt ons gezond?
Vitaminen en mineralen zijn erg belangrijk voor onze gezondheid, maar het is niet zo makkelijk om voldoende groenten en fruit te eten. Voedingspillen zijn een welkom alternatief, maar kunnen ze een uitgebalanceerd dieet compenseren?
Keuzes maken zonder hersenen – De geheime boodschappers van planten
Hoe neem je beslissingen als je niet kunt denken? Hoe reageer je op gevaar als je je niet kan bewegen of verstoppen? Planten kennen het geheim. Fundamentele onderzoekers over de hele wereld proberen dat te begrijpen.
Ongeboren vrucht
Laatst zag ik een klein glazen potje met iets behoorlijk bizars erin.
Ik had het mis – online congressen
Enkele jaren gelden vroeg een collega’s zich af waarom we nog de wereld over reizen om congressen bij te wonen. Ik sprong er meteen op in en reageerde fel dat bijeenkomsten noodzakelijk zijn voor de wetenschap. Ik was volledig overtuigd van mijn gelijk.
Licht werpen op vlinders
Vlinders zijn er in alle vormen en kleuren. Moeder Natuur heeft trucjes om die vlinders, en de rest van de wereld in te kleuren.
Wetenschappers vergeten een belangrijk component bij de jacht naar het coronavaccin
Wetenschappers publiceerden al talloze 3D-modellen van delen van het nieuwe coronavirus. Die modellen zjin essentieel bij het maken van een coronavaccin. Maar ze missen iets belangrijks…
Waarom wetenschappers GGO’s maken voor onderzoek in het laboratorium
Genetisch gemodificeerde organismen (GGO’s) zijn krachtige hulpmiddelen die wetenschappers helpen de basis van het leven te bestuderen. De kennis die ze ermee opdoen, is de basis die leidt tot verschillende toepassingen voor iedereen.
Verveling door corona-isolatie? Word wetenschapper voor een dag (of langer).
Wetenschappers plaatsen grote hoeveelheden data in app ‘Zooniverse’ en roepen onze hulp in om die te analyseren. Daarmee kun je bijdragen aan jouw favoriete veld, bijvoorbeeld biologie, kunst, astronomie of gezondheid.
Mijn blog volgen
Krijg nieuwe content direct in je mailbox.